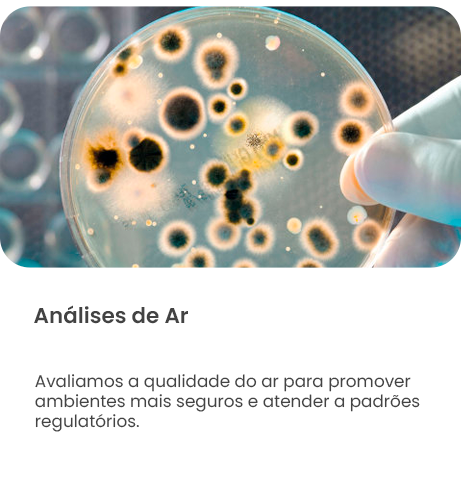
6

NOSSOS
DIFERENCIAIS
O Laboratório nasceu com um propósito de oferecer ao cliente algo além de resultados analíticos, diferencial expresso em nossa frase de efeito: “Mais que resultados, soluções!”.
Desta forma, nos comprometemos a auxiliar na resolução de não conformidades detectadas, seja através de consultoria ou de parceria com empresas qualificadas e especializadas em tratamentos.
Cartas de Elaboração
Elaboração de cartas de avaliação, elucidando não conformidades e outras duvidas técnicas referentes aos relatórios de ensaio.
Política Facilitadora
Implementação de uma politica facilitadora de comunicação entre cliente e equipe especializada, o que resulta em uma rapidez nos serviços.